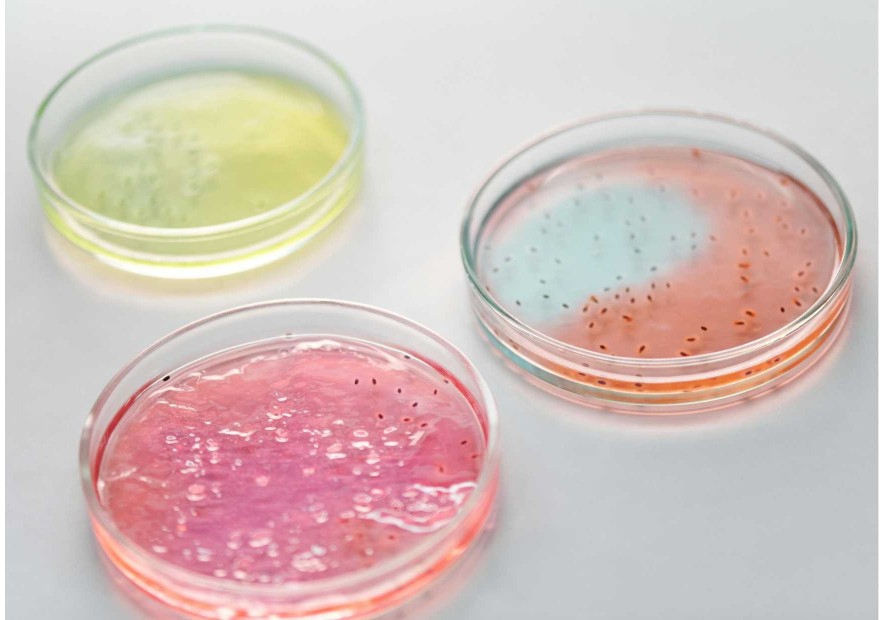

Pourquoi diminuer les conservateurs en cosmétique ?
Dans notre quête d’une peau éclatante et en bonne santé, nous faisons de plus en plus attention aux ingrédients présents dans nos soins. Parmi eux, les conservateurs cosmétiques sont au cœur des débats. Présents pour prolonger la durée de vie des produits, certains peuvent toutefois impacter l’équilibre de la peau. Alors, pourquoi réduire leur présence dans notre routine beauté ? Quels sont les bénéfices pour la flore cutanée ? Et comment adopter une routine plus respectueuse ? On vous dit tout !
1. Pourquoi des conservateurs sont utilisés en cosmétique ?
Les conservateurs sont indispensables dans les cosmétiques contenant de l’eau pour éviter la prolifération de bactéries, de champignons et de moisissures. Sans conservateurs, un produit pourrait se dégrader rapidement et devenir dangereux pour la peau. Leur rôle est donc crucial pour garantir la sécurité et l’efficacité des soins de beauté.
Toutefois, certains conservateurs peuvent avoir des effets indésirables et perturber l’équilibre naturel de la peau.
2. Les grandes familles de conservateurs en cosmétique
Il existe plusieurs types de conservateurs utilisés en cosmétique, classés en différentes familles :
- Les parabènes : largement utilisés pour leur efficacité antimicrobienne, mais controversés en raison de leur potentiel perturbateur endocrinien.
- Les libérateurs de formaldéhyde : comme l’Imidazolidinyl Urea ou le DMDM Hydantoin, ils libèrent progressivement du formaldéhyde, un agent conservateur puissant mais irritant.
- Les alcools et glycols : comme l’alcool benzylique ou le propylène glycol, qui ont des propriétés antimicrobiennes mais peuvent être desséchants pour la peau.
- Les phénols et dérivés : comme le phénoxyéthanol, couramment utilisé mais réglementé en raison de son potentiel irritant.
3. Les conservateurs en cosmétique : quel impact sur votre peau ?
Les conservateurs sont utilisés pour empêcher la prolifération de bactéries et prolonger la durée de vie des cosmétiques. Toutefois, certains conservateurs synthétiques (parabènes, phénoxyéthanol, libérateurs de formaldéhyde…) peuvent avoir des effets indésirables sur la peau :
- Déséquilibre de la flore cutanée : la peau abrite un microbiome composé de bactéries bénéfiques qui participent à sa santé. Certains conservateurs agressifs peuvent perturber cet équilibre et fragiliser la barrière cutanée.
- Irritations et sensibilités : les peaux sensibles ou réactives peuvent mal tolérer certains conservateurs, entraînant rougeurs, sécheresse ou inconfort.
- Perturbateurs endocriniens potentiels : certains conservateurs controversés sont suspectés d’avoir un impact sur le système hormonal.
4. Quels conservateurs sont tolérés en cosmétique bio ?
Les cosmétiques bio interdisent les conservateurs synthétiques jugés trop agressifs et privilégient des alternatives plus naturelles. Parmi les 59 conservateurs autorisés en cosmétique européenne, seuls 5 sont autorisés dans les produits certifiés bio.
Voici la liste :
✅ L'acide salicylique (Nom INCI: Salicylic Acid)
✅ Benzoate de sodium (Nom INCI : Sodium Benzoate )
✅ Sorbate de potassium (Nom INCI : Potassium Sorbate)
✅ L’alcool benzylique (nom INCI : benzyl alcohol)
✅ L' acide déhydroacétique (nom INCI : Dehydroacetic acid)
Ces conservateurs sont moins controversés et permettent une conservation efficace. Ils sont moins impactants pour la santé de votre peau cependant certaines peaux y sont tout de même sensibles.
Heureusement, il est possible d’adopter une routine plus respectueuse de la peau en limitant les conservateurs inutiles.
5. Moins de conservateurs, une peau plus équilibrée
Réduire l’utilisation de conservateurs dans les soins cosmétiques présente plusieurs avantages :
✅ Respect du microbiome cutané : une peau en bonne santé est une peau équilibrée. Moins de conservateurs signifie moins d’agressions pour la flore naturelle, favorisant une peau plus résistante et éclatante.
✅ Moins d’irritations et de réactions : pour les peaux sensibles ou sujettes aux rougeurs, une routine sans conservateurs limite les risques de sensibilisation.
✅ Des ingrédients plus purs et efficaces : en réduisant les conservateurs, on privilégie des formules plus concentrées en actifs bénéfiques, sans composants inutiles.
Pourquoi une flore équilibrée est importante pour la santé de la peau
6. Adopter une routine sans conservateur avec La Bo&ssie
Chez La Bo&ssie, nous croyons en une cosmétique respectueuse de la peau et de son équilibre naturel. C’est pourquoi nous proposons une routine sans conservateurs, formulée pour préserver la flore cutanée et sublimer la peau :
✨ L’huile démaquillante: un démaquillage doux et efficace, sans agresser la peau ni perturber son microbiome. Elle élimine impuretés et maquillage tout en respectant l’équilibre naturel de la peau.
✨Les soins sérums probiotiques: de véritables alliés pour renforcer la flore cutanée et restaurer l’équilibre de la peau. Enrichi en probiotiques, il nourrit, apaise et protège sans besoin de conservateurs artificiels.
Avec cette routine minimaliste, votre peau retrouve son éclat naturel et sa santé, sans compromis !
7. FAQ : Vos questions sur les conservateurs en cosmétique
1. Les conservateurs sont-ils vraiment dangereux pour la peau ?
Tout dépend du type de conservateur. Certains peuvent perturber la flore cutanée ou être irritants, tandis que d'autres, d'origine naturelle, sont bien tolérés.
2. Peut-on utiliser des cosmétiques sans conservateur ?
Oui, si la formule ne contient pas d’eau, comme les huiles ou certains sérums anhydres. Sinon, des conservateurs doux sont nécessaires pour éviter la prolifération bactérienne.
3. Comment savoir si un cosmétique contient des conservateurs nocifs ?
Vérifiez la liste INCI des ingrédients et repérez les parabènes, phénoxyéthanol ou libérateurs de formaldéhyde.
4. Une routine sans conservateurs convient-elle aux peaux sensibles ?
Absolument ! Moins de conservateurs signifie moins d’irritants, ce qui est idéal pour les peaux réactives.
8. Conclusion : une beauté plus respectueuse
Diminuer les conservateurs en cosmétique, c’est faire un choix éclairé pour préserver l’équilibre de sa peau et favoriser une approche plus naturelle de la beauté. Grâce aux soins La Bo&ssie, adoptez une routine minimaliste et efficace, qui respecte votre peau tout en la sublimant.
Prêt(e) à passer à une routine sans conservateurs ?







.jpg)







